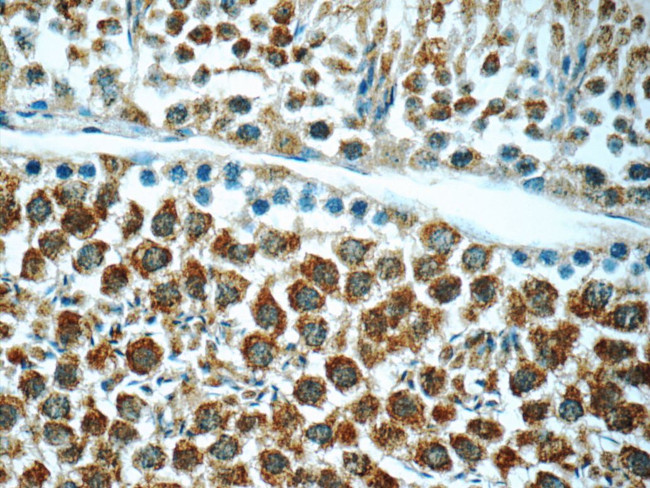
ANKRD54 Antibody in Immunohistochemistry (Paraffin) (IHC (P))

Search
Proteintech
ANKRD54 Polyclonal Antibody
{{$productOrderCtrl.translations['antibody.pdp.commerceCard.promotion.promotions']}}
{{$productOrderCtrl.translations['antibody.pdp.commerceCard.promotion.viewpromo']}}
{{$productOrderCtrl.translations['antibody.pdp.commerceCard.promotion.promocode']}}: {{promo.promoCode}} {{promo.promoTitle}} {{promo.promoDescription}}. {{$productOrderCtrl.translations['antibody.pdp.commerceCard.promotion.learnmore']}}
产品信息
25738-1-AP
种属反应
宿主/亚型
分类
类型
抗原
偶联物
形式
浓度
规格
纯化类型
保存液
内含物
保存条件
运输条件
产品详细信息
Immunogen sequence: RVDALDRAG RTPLHLAKSK LNILQEGHAQ CLEAVRLEVK QIIHMLREYL ERLGQHEQRE RLDDLCTRLQ MTSTKEQVDE VTDLLASFTS LSLQMQSMEK R (201-300 aa encoded by BC066909)
靶标信息
Ankyrin (ANK) repeats mediate protein-protein interactions in diverse families of proteins. The number of ANK repeats in a protein can range from 2 to over 20. ANK repeats may occur in combinations with other types of domains. The structural repeat unit contains two anti-parallel helices and a beta-hairpin, with repeats stacked in a superhelical arrangement. LIAR, also known as ANKRD54, is a recently identified ANK repeat-containing protein that is predominantly expressed in tissues rich in ciliated cells, such as olfactory sensory neurons and is predicted to be important to cilia. At least three isoforms of LIAR are known to exist.
仅用于科研。不用于诊断过程。未经明确授权不得转售。
篇参考文献 (0)
生物信息学
蛋白别名: Ankyrin repeat domain-containing protein 54; dJ466N1.4; Lyn-interacting ankyrin repeat protein; unnamed protein product
基因别名: ANKRD54; C730048E16Rik; EST1068184; EST475269; LIAR
UniProt ID: (Human) Q6NXT1, (Mouse) Q91WK7
Entrez Gene ID: (Human) 129138, (Mouse) 223690